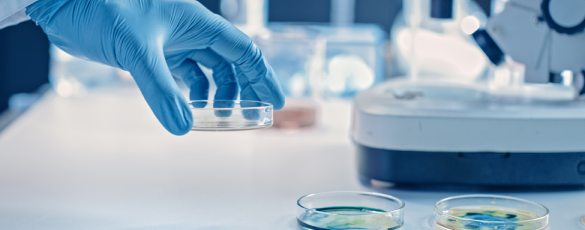
carousel images

Repercussions of the pandemic are considerably changing the way the Life Sciences and Pharma industries function. In order to survive the current market fluctuations and remain relevant, businesses need to make a digital shift. The increasing cost of adopting new-age technologies reduces the scope of growth of enterprises. This affects their efficiency, ability to deliver personalized treatments, and crisis management operations. The gaps in health equity have only multiplied and need to be minimized with the help of innovative solutions.